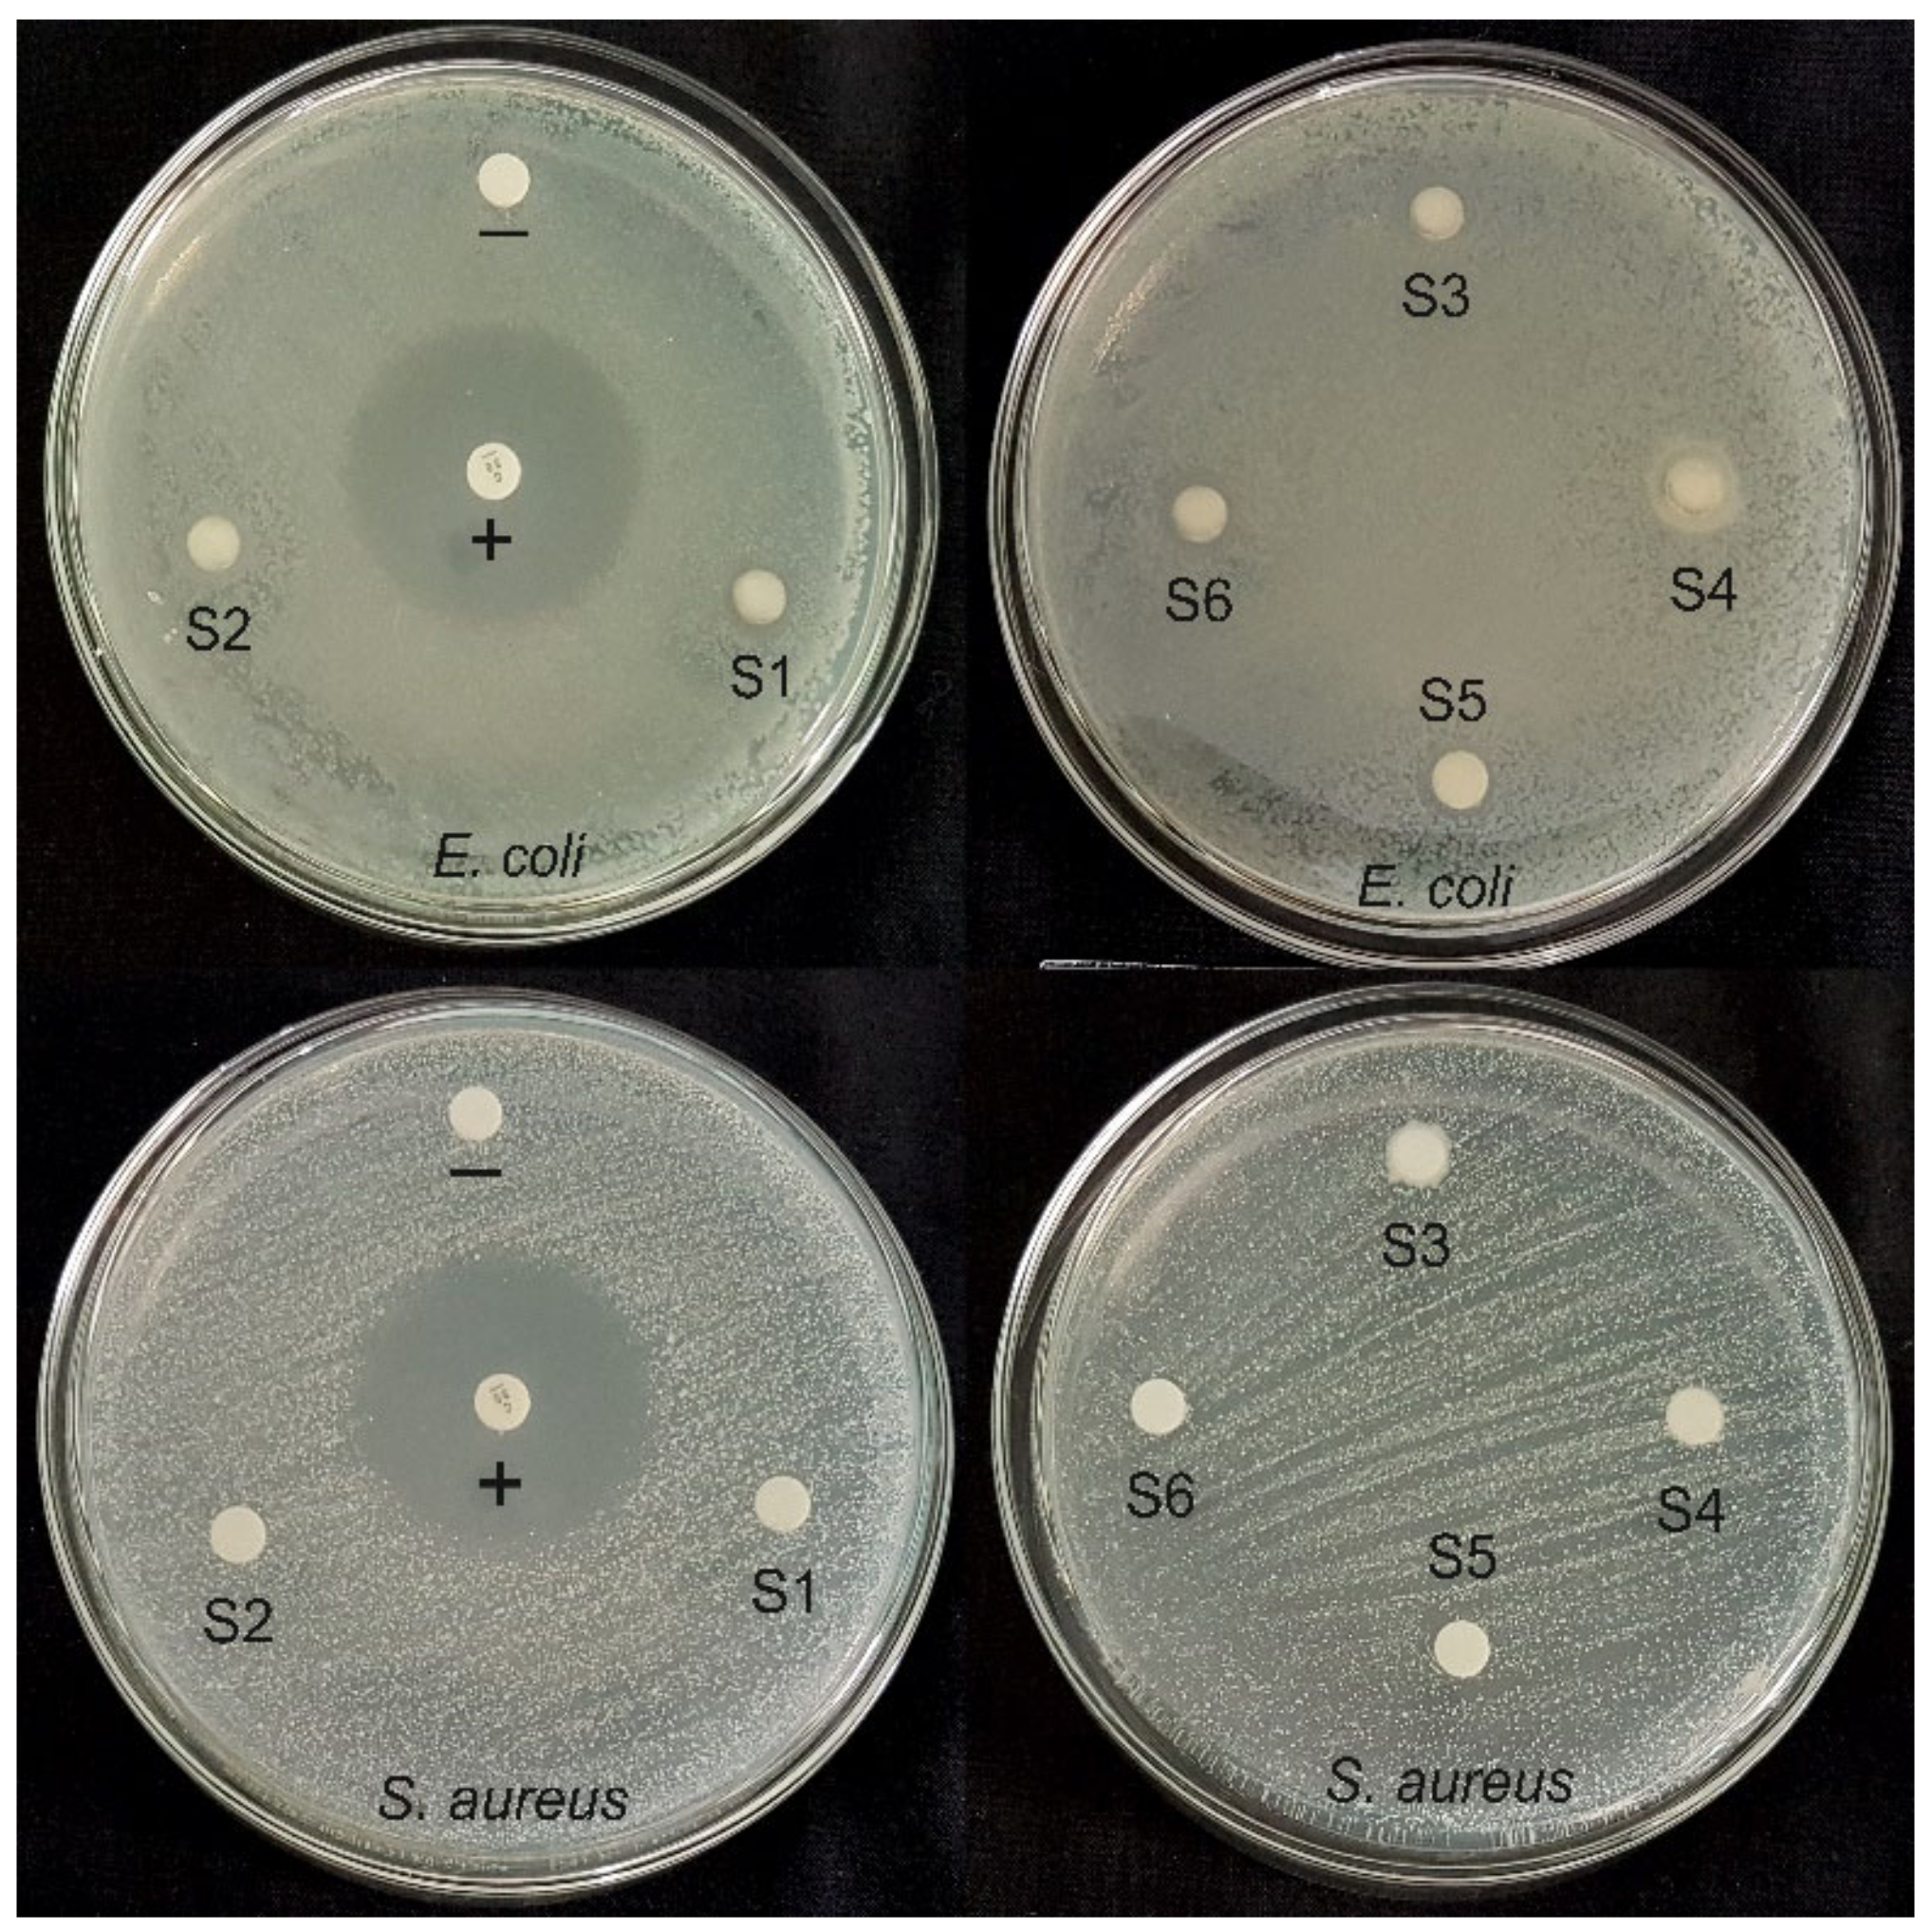
Coatings 12 00680 g006

Physicochemical Characterization and Antibacterial Activity of Titanium/Shellac-Coated Hydroxyapatite Composites
Abstract
:1. Introduction
2. Experimental Section
2.1. Preparation of Materials
2.2. Characterization
2.3. Antibacterial Activity
3. Results and Discussion
3.1. Physicochemical Characteristics
3.2. Antibacterial Activities
4. Conclusions
Author Contributions
Funding
Institutional Review Board Statement
Informed Consent Statement
Data Availability Statement
Conflicts of Interest
References
- Diago, A.M.D.; Generali, L.; Apponi, R.; Colombini, V.; Checchi, V. Traumatic Dental Injuries: Clinical Case Presentation and a 10-Year Epidemiological Investigation in an Italian Dental Emergency Service. Case Rep. Dent. 2021, 2021, 86496632021. [Google Scholar] [CrossRef]
- Zaleckiene, V.; Peciuliene, V.; Brukiene, V.; Drukteinis, S. Traumatic dental injuries: Etiology, prevalence and possible outcomes. Stomatologija 2014, 16, 7–14. [Google Scholar] [PubMed]
- Wang, X.; Wan, C.; Feng, X.; Zhao, F.; Wang, H. In Vivo and In Vitro Analyses of Titanium-Hydroxyapatite Functionally Graded Material for Dental Implants. BioMed Res. Int. 2021, 2021, 8859945. [Google Scholar] [CrossRef] [PubMed]
- Arifin, A.; Sulong, A.B.; Muhamad, N.; Syarif, J.; Ramli, M.I. Material processing of hydroxyapatite and titanium alloy (HA/Ti) composite as implant materials using powder metallurgy: A review. Mater. Des. 2014, 55, 165–175. [Google Scholar] [CrossRef]
- Mondal, A.; Sohel, A.; Mohammed, A.P.; Anu, A.S.; Thomas, S.; Sengupta, A. Crystallization study of shellac investigated by differential scanning calorimetry. Polym. Bull. 2019, 77, 5127–5143. [Google Scholar] [CrossRef]
- İzmir, M.; Ercan, B. Anodization of titanium alloys for orthopedic applications. Front. Chem. Sci. Eng. 2019, 13, 28–45. [Google Scholar] [CrossRef]
- Hsu, H.-C.; Hsu, S.-K.; Wu, S.-C.; Wang, P.-H.; Ho, W.-F. Design and characterization of highly porous titanium foams with bioactive surface sintering in air. J. Alloy. Compd. 2013, 575, 326–332. [Google Scholar] [CrossRef]
- Farias, K.A.S.; Sousa, W.J.B.; Cardoso, M.J.B.; Lima, R.J.S.; Rodriguez, M.A.; Fook, M.V.L. Obtaining hydroxyapatite with different precursors for application as a biomaterial. Ceramica 2019, 65, 99–106. [Google Scholar] [CrossRef]
- Kumar, G.S.; Thamizhavel, A.; Girija, E. Microwave conversion of eggshells into flower-like hydroxyapatite nanostructure for biomedical applications. Mater. Lett. 2012, 76, 198–200. [Google Scholar] [CrossRef]
- Biedrzycka, A.; Skwarek, E.; Osypiuk, D.; Cristóvao, B. Synthesis of Hydroxyapatite/Iron Oxide Composite and Comparison of Selected Structural, Surface, and Electrochemical Properties. Materials 2022, 15, 1139. [Google Scholar] [CrossRef]
- Sazesh, S.; Ghassemi, A.; Ebrahimi, R.; Khodaei, M. Fabrication and characterization of nHA/titanium dental implant. Mater. Res. Express 2019, 6, 045060. [Google Scholar] [CrossRef]
- Anawati; Tanigawa, H.; Asoh, H.; Ohno, T.; Kubota, M.; Ono, S. Electrochemical corrosion and bioactivity of titanium-hydroxyapatite composites prepared by spark plasma sintering. Corros. Sci. 2013, 70, 212–220. [Google Scholar] [CrossRef]
- Arifin, A.; Sulong, A.B.; Muhamad, N.; Syarif, J.; Ramli, M.I. Powder injection molding of HA/Ti6Al4V composite using palm stearin as based binder for implant material. Mater. Des. 2015, 65, 1028–1034. [Google Scholar] [CrossRef]
- Weththimuni, M.L.; Capsoni, D.; Malagodi, M.; Milanese, C.; Licchelli, M. Shellac/nanoparticles dispersions as protective materials for wood. Appl. Phys. A Mater. Sci. Process 2016, 122, 1058. [Google Scholar] [CrossRef]
- Comín, R.; Cid, M.P.; Grinschpun, L.; Oldani, C.; Salvatierra, N.A. Titanium-Hydroxyapatite Composites Sintered at Low Temperature for Tissue Engineering: In vitro Cell Support and Biocompatibility. J. Appl. Biomater. Funct. Mater. 2017, 15, e176–e183. [Google Scholar] [CrossRef]
- Lamkhao, S.; Phaya, M.; Jansakun, C.; Chandet, N.; Thongkorn, K.; Rujijanagul, G.; Bangrak, P.; Randorn, C. Synthesis of Hydroxyapatite with Antibacterial Properties Using a Microwave-Assisted Combustion Method. Sci. Rep. 2019, 9, 4015. [Google Scholar] [CrossRef] [Green Version]
- Ashraf, R.; Sofi, H.S.; Akram, T.; Rather, H.A.; Abdal-Hay, A.; Shabir, N.; Vasita, R.; Alrokayan, S.H.; Khan, H.A.; Sheikh, F.A. Fabrication of multifunctional cellulose/TiO2/Ag composite nanofibers scaffold with antibacterial and bioactivity properties for future tissue engineering applications. J. Biomed. Mater. Res. Part A 2020, 108, 947–962. [Google Scholar] [CrossRef]
- Triyono, J.; Susmartini, S.; Susilowati, E.; Murdiyantara, S.A. Shellac Coated Hydroxyapatite (HA) Scaffold for Increasing Compression Strength. Adv. Mater. Res. 2015, 1123, 378–382. [Google Scholar] [CrossRef]
- Parvizifard, M.; Karbasi, S.; Salehi, H.; Bakhtiari, S.S.E. Evaluation of physical, mechanical and biological properties of bioglass/titania scaffold coated with poly (3-hydroxybutyrate)-chitosan for bone tissue engineering applications. Mater. Technol. 2019, 35, 75–91. [Google Scholar] [CrossRef]
- Murugan, N.; Murugan, C.; Sundramoorthy, A.K. In vitro and in vivo characterization of mineralized hydroxyapatite/polycaprolactone-graphene oxide based bioactive multifunctional coating on Ti alloy for bone implant applications. Arab. J. Chem. 2018, 11, 959–969. [Google Scholar] [CrossRef]
- Peng, Q.; Bin, X.; Xuxing, H.; Wang, Y.; Peng, Z.; Tang, Z. Facile fabrication of boronized Ti6Al4V/HA composites for load-bearing applications. J. Alloy. Compd. 2020, 825, 153102. [Google Scholar] [CrossRef]
- Anaee, R.A. Behavior of Ti/HA in Saliva at Different Temperatures as Restorative Materials. J. Bio Tribo Corros. 2016, 2, 5. [Google Scholar] [CrossRef] [Green Version]
- Mondal, D.; Patel, M.; Jain, H.; Jha, A.; Das, S.; Dasgupta, R. The effect of the particle shape and strain rate on microstructure and compressive deformation response of pure Ti-foam made using acrowax as space holder. Mater. Sci. Eng. A 2014, 625, 331–342. [Google Scholar] [CrossRef]
- Kumar, C.G.; Pombala, S.; Poornachandra, Y.; Agarwal, S.V. Synthesis, characterization, and applications of nanobiomaterials for antimicrobial therapy. Nanobio Mater. Antimicrob. Ther. 2016, 6, 103–152. [Google Scholar] [CrossRef]
- Aygul, E.; Yalcinkaya, S.; Sahin, Y. Microstructural analysis of sintered pure-titanium and titanium/hydroxyapatite (HA) surgical implant materials under different temperatures and HA doped conditions produced by powder metallurgy. Mater. Res. Express 2020, 7, 035402. [Google Scholar] [CrossRef]
- Sarkar, P.; Shrivastava, A. FTIR spectroscopy of lac resin and its derivatives. Pigment Resin Technol. 1997, 26, 378–381. [Google Scholar] [CrossRef]
- Stevanović, M.; Djošić, M.; Janković, A.; Kojić, V.; Vukašinović-Sekulić, M.; Stojanović, J.; Odović, J.; Sakač, M.C.; Yop, R.K.; Mišković-Stanković, V. Antibacterial graphene-based hydroxyapatite/chitosan coating with gentamicin for potential applications in bone tissue engineering. J. Biomed. Mater. Res. Part A 2020, 108, 2175–2189. [Google Scholar] [CrossRef]
- Enayati-Jazi, M.; Solati-Hashjin, M.; Nemati, A.; Bakhshi, F. Synthesis and characterization of hydroxyapatite/titania nanocomposites using in situ precipitation technique. Superlattices Microstruct. 2012, 51, 877–885. [Google Scholar] [CrossRef]
- Artimani, J.S.; Ardjmand, M.; Enhessari, M.; Javanbakht, M. Polybenzimidazole/BaCe0.85Y0.15O3-δ nanocomposites with enhanced proton conductivity for high-temperature PEMFC application. Can. J. Chem. 2019, 97, 520–528. [Google Scholar] [CrossRef]
- Ye, H.; Liu, X.Y.; Hong, H. Characterization of sintered titanium/hydroxyapatite biocomposite using FTIR spectroscopy. J. Mater. Sci. Mater. Electron. 2008, 20, 843–850. [Google Scholar] [CrossRef] [Green Version]
- Yılmaz, E.; Kabataş, F.; Gökçe, A.; Fındık, F. Production and Characterization of a Bone-Like Porous Ti/Ti-Hydroxyapatite Functionally Graded Material. J. Mater. Eng. Perform. 2020, 29, 6455–6467. [Google Scholar] [CrossRef]
- Brangule, A.; Gross, K.A. Importance of FTIR Spectra Deconvolution for the Analysis of Amorphous Calcium Phosphates. IOP Conf. Ser. Mater. Sci. Eng. 2015, 77, 012027. [Google Scholar] [CrossRef] [Green Version]
- Wibowo, W.; Lenggana, B.W.; Ubaidillah, U.; Ariawan, D.; Imaduddin, F.; Mazlan, S.A.; Choi, S.-B. Declining Performance of Silicone-Based Magnetorheological Elastomers after Accelerated Weathering. Materials 2021, 14, 6389. [Google Scholar] [CrossRef] [PubMed]
- Pastero, L.; Bruno, M.; Aquilano, D. About the Genetic Mechanisms of Apatites: A Survey on the Methodological Approaches. Minerals 2017, 7, 139. [Google Scholar] [CrossRef] [Green Version]
- Fleet, M.E.; Liu, X. Location of type B carbonate ion in type A–B carbonate apatite synthesized at high pressure. J. Solid State Chem. 2004, 177, 3174–3182. [Google Scholar] [CrossRef]
- Laskus, A.; Kolmas, J. Ionic Substitutions in Non-Apatitic Calcium Phosphates. Int. J. Mol. Sci. 2017, 18, 2542. [Google Scholar] [CrossRef] [Green Version]
- Bovand, D.; Yousefpour, M.; Rasouli, S.; Bagherifard, S.; Bovand, N.; Tamayol, A. Characterization of Ti-HA composite fabricated by mechanical alloying. Mater. Des. 2015, 65, 447–453. [Google Scholar] [CrossRef]
- Niespodziana, K.; Jurczyk, K.; Jakubowicz, J.; Jurczyk, M. Fabrication and properties of titanium–hydroxyapatite nanocomposites. Mater. Chem. Phys. 2010, 123, 160–165. [Google Scholar] [CrossRef]
- Tamer, T.M. Development of polyvinyl alcohol/kaolin sponges stimulated by marjoram as hemostatic, antibacterial, and antioxidant dressings for wound healing promotion. Int. J. Mol. Sci. 2021, 22, 13050. [Google Scholar] [CrossRef]
- Azizi-Lalabadi, M.; Ehsani, A.; Divband, B.; Alizadeh-Sani, M. Antimicrobial activity of Titanium dioxide and Zinc oxide nanoparticles supported in 4A zeolite and evaluation the morphological characteristic. Sci. Rep. 2019, 9, 7439. [Google Scholar] [CrossRef] [Green Version]
- Dhanker, R.; Hussain, T.; Tyagi, P.; Singh, K.T.; Kamble, S.S. The Emerging Trend of Bio-Engineering Approaches for Microbial Nanomaterial Synthesis and Its Applications. Front. Microbiol. 2021, 12, 638003. [Google Scholar] [CrossRef] [PubMed]
- Choudhary, R.; Venkatraman, S.K.; Chatterjee, A.; Vecstaudza, J.; Yáñez-Gascón, M.J.; Pérez-Sánchez, H.; Locs, J.; Abraham, J.; Swamiappan, S. Biomineralization, antibacterial activity and mechanical properties of biowaste derived diopside nanopowders. Adv. Powder Technol. 2019, 30, 1950–1964. [Google Scholar] [CrossRef]
- Biedrzycka, A.; Skwarek, E.; Hanna, U.M. Hydroxyapatite with magnetic core: Synthesis methods, properties, adsorption and medical applications. Adv. Colloid Interface Sci. 2021, 291, 102401. [Google Scholar] [CrossRef] [PubMed]

| Sample | Ti:HA Composition (v/v)% | Sintering Temperature (°C) | Sintering Time (h) |
|---|---|---|---|
| S1 | 80:20 | 800 | 3 |
| S2 | 80:20 | 800 | 4 |
| S3 | 80:20 | 800 | 5 |
| S4 | 70:30 | 800 | 3 |
| S5 | 70:30 | 800 | 4 |
| S6 | 70:30 | 800 | 5 |
| Ti-HA Composite Sample | Crystallite Size (nm) |
|---|---|
| S1 | 13.5 |
| S2 | 22.2 |
| S3 | 27.3 |
| S4 | 18.7 |
| S5 | 14.7 |
| S6 | 10.7 |
Publisher’s Note: MDPI stays neutral with regard to jurisdictional claims in published maps and institutional affiliations. |
© 2022 by the authors. Licensee MDPI, Basel, Switzerland. This article is an open access article distributed under the terms and conditions of the Creative Commons Attribution (CC BY) license (https://creativecommons.org/licenses/by/4.0/).
Share and Cite
Harwijayanti, W.; Ubaidillah, U.; Triyono, J. Physicochemical Characterization and Antibacterial Activity of Titanium/Shellac-Coated Hydroxyapatite Composites. Coatings 2022, 12, 680. https://doi.org/10.3390/coatings12050680
Harwijayanti W, Ubaidillah U, Triyono J. Physicochemical Characterization and Antibacterial Activity of Titanium/Shellac-Coated Hydroxyapatite Composites. Coatings. 2022; 12(5):680. https://doi.org/10.3390/coatings12050680
Chicago/Turabian StyleHarwijayanti, Widyanita, Ubaidillah Ubaidillah, and Joko Triyono. 2022. "Physicochemical Characterization and Antibacterial Activity of Titanium/Shellac-Coated Hydroxyapatite Composites" Coatings 12, no. 5: 680. https://doi.org/10.3390/coatings12050680
APA StyleHarwijayanti, W., Ubaidillah, U., & Triyono, J. (2022). Physicochemical Characterization and Antibacterial Activity of Titanium/Shellac-Coated Hydroxyapatite Composites. Coatings, 12(5), 680. https://doi.org/10.3390/coatings12050680

